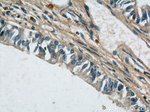
MUC8 Antibody in Immunohistochemistry (Paraffin) (IHC (P))

Search
Proteintech
MUC8 Polyclonal Antibody
{{$productOrderCtrl.translations['antibody.pdp.commerceCard.promotion.promotions']}}
{{$productOrderCtrl.translations['antibody.pdp.commerceCard.promotion.viewpromo']}}
{{$productOrderCtrl.translations['antibody.pdp.commerceCard.promotion.promocode']}}: {{promo.promoCode}} {{promo.promoTitle}} {{promo.promoDescription}}. {{$productOrderCtrl.translations['antibody.pdp.commerceCard.promotion.learnmore']}}
产品信息
55489-1-AP
种属反应
宿主/亚型
分类
类型
抗原
偶联物
形式
浓度
规格
纯化类型
保存液
内含物
保存条件
运输条件
产品详细信息
This antibody is specific to MUC8.
靶标信息
Mucin glycoproteins (Mucins) are major constituents of the glycocalyx that covers mucosal epithelium. MUC8 is one of the major mucins in the ethmoid mucosa and is upregulated by chronic inflammation. TNFa, IL-1b and a combination of both can significantly increase Mucin 8 mRNA levels, suggesting that a mixture of inflammatory mediators can synergistically increase secretion of mucin in human nasal epithelium.
仅用于科研。不用于诊断过程。未经明确授权不得转售。
生物信息学
Entrez Gene ID: (Human) 100129528